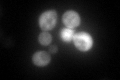
YPL226W
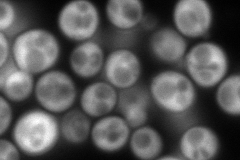
YPL226W
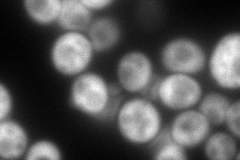
YPL226W
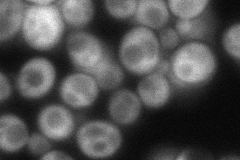
YPL226W
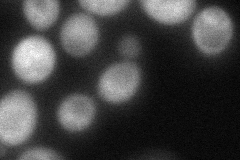
YPL226W
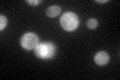
YPL226W

View description
ATP binding cassette family member; Asn/Gln-rich rich region supports [NU+] prion formation and susceptibility to [PSI+] prion induction; homologous to mRNA export factor from S. pombe and similar protein from C. albicans
Localization:
Intensity:
Fold change:
Significance:
-
C’ GFP library in SD
cytosol22.19 -
N' NOP1pr-GFP in SD
cytosol249.159 -
N' TEF2pr-mCherry in SD
cytosol186.079 -
N' NATIVEpr-GFP in SD
cytosol81.9143 -
N' TEF2pr-VC and Cyto-VN in SD
cytosol72.3674 -
C’ GFP library in SD+DTT

cytosol24.781.11No -
C’ GFP library in SD+H2O2

cytosol21.810.98No -
C’ GFP library in Starvation Media
cytosol107.264.83Yes -
C’ GFP library on the background of Pup2-DaMP

N/A -
C’ GFP library on the background of CCT mutant

N/A0N/AYes
